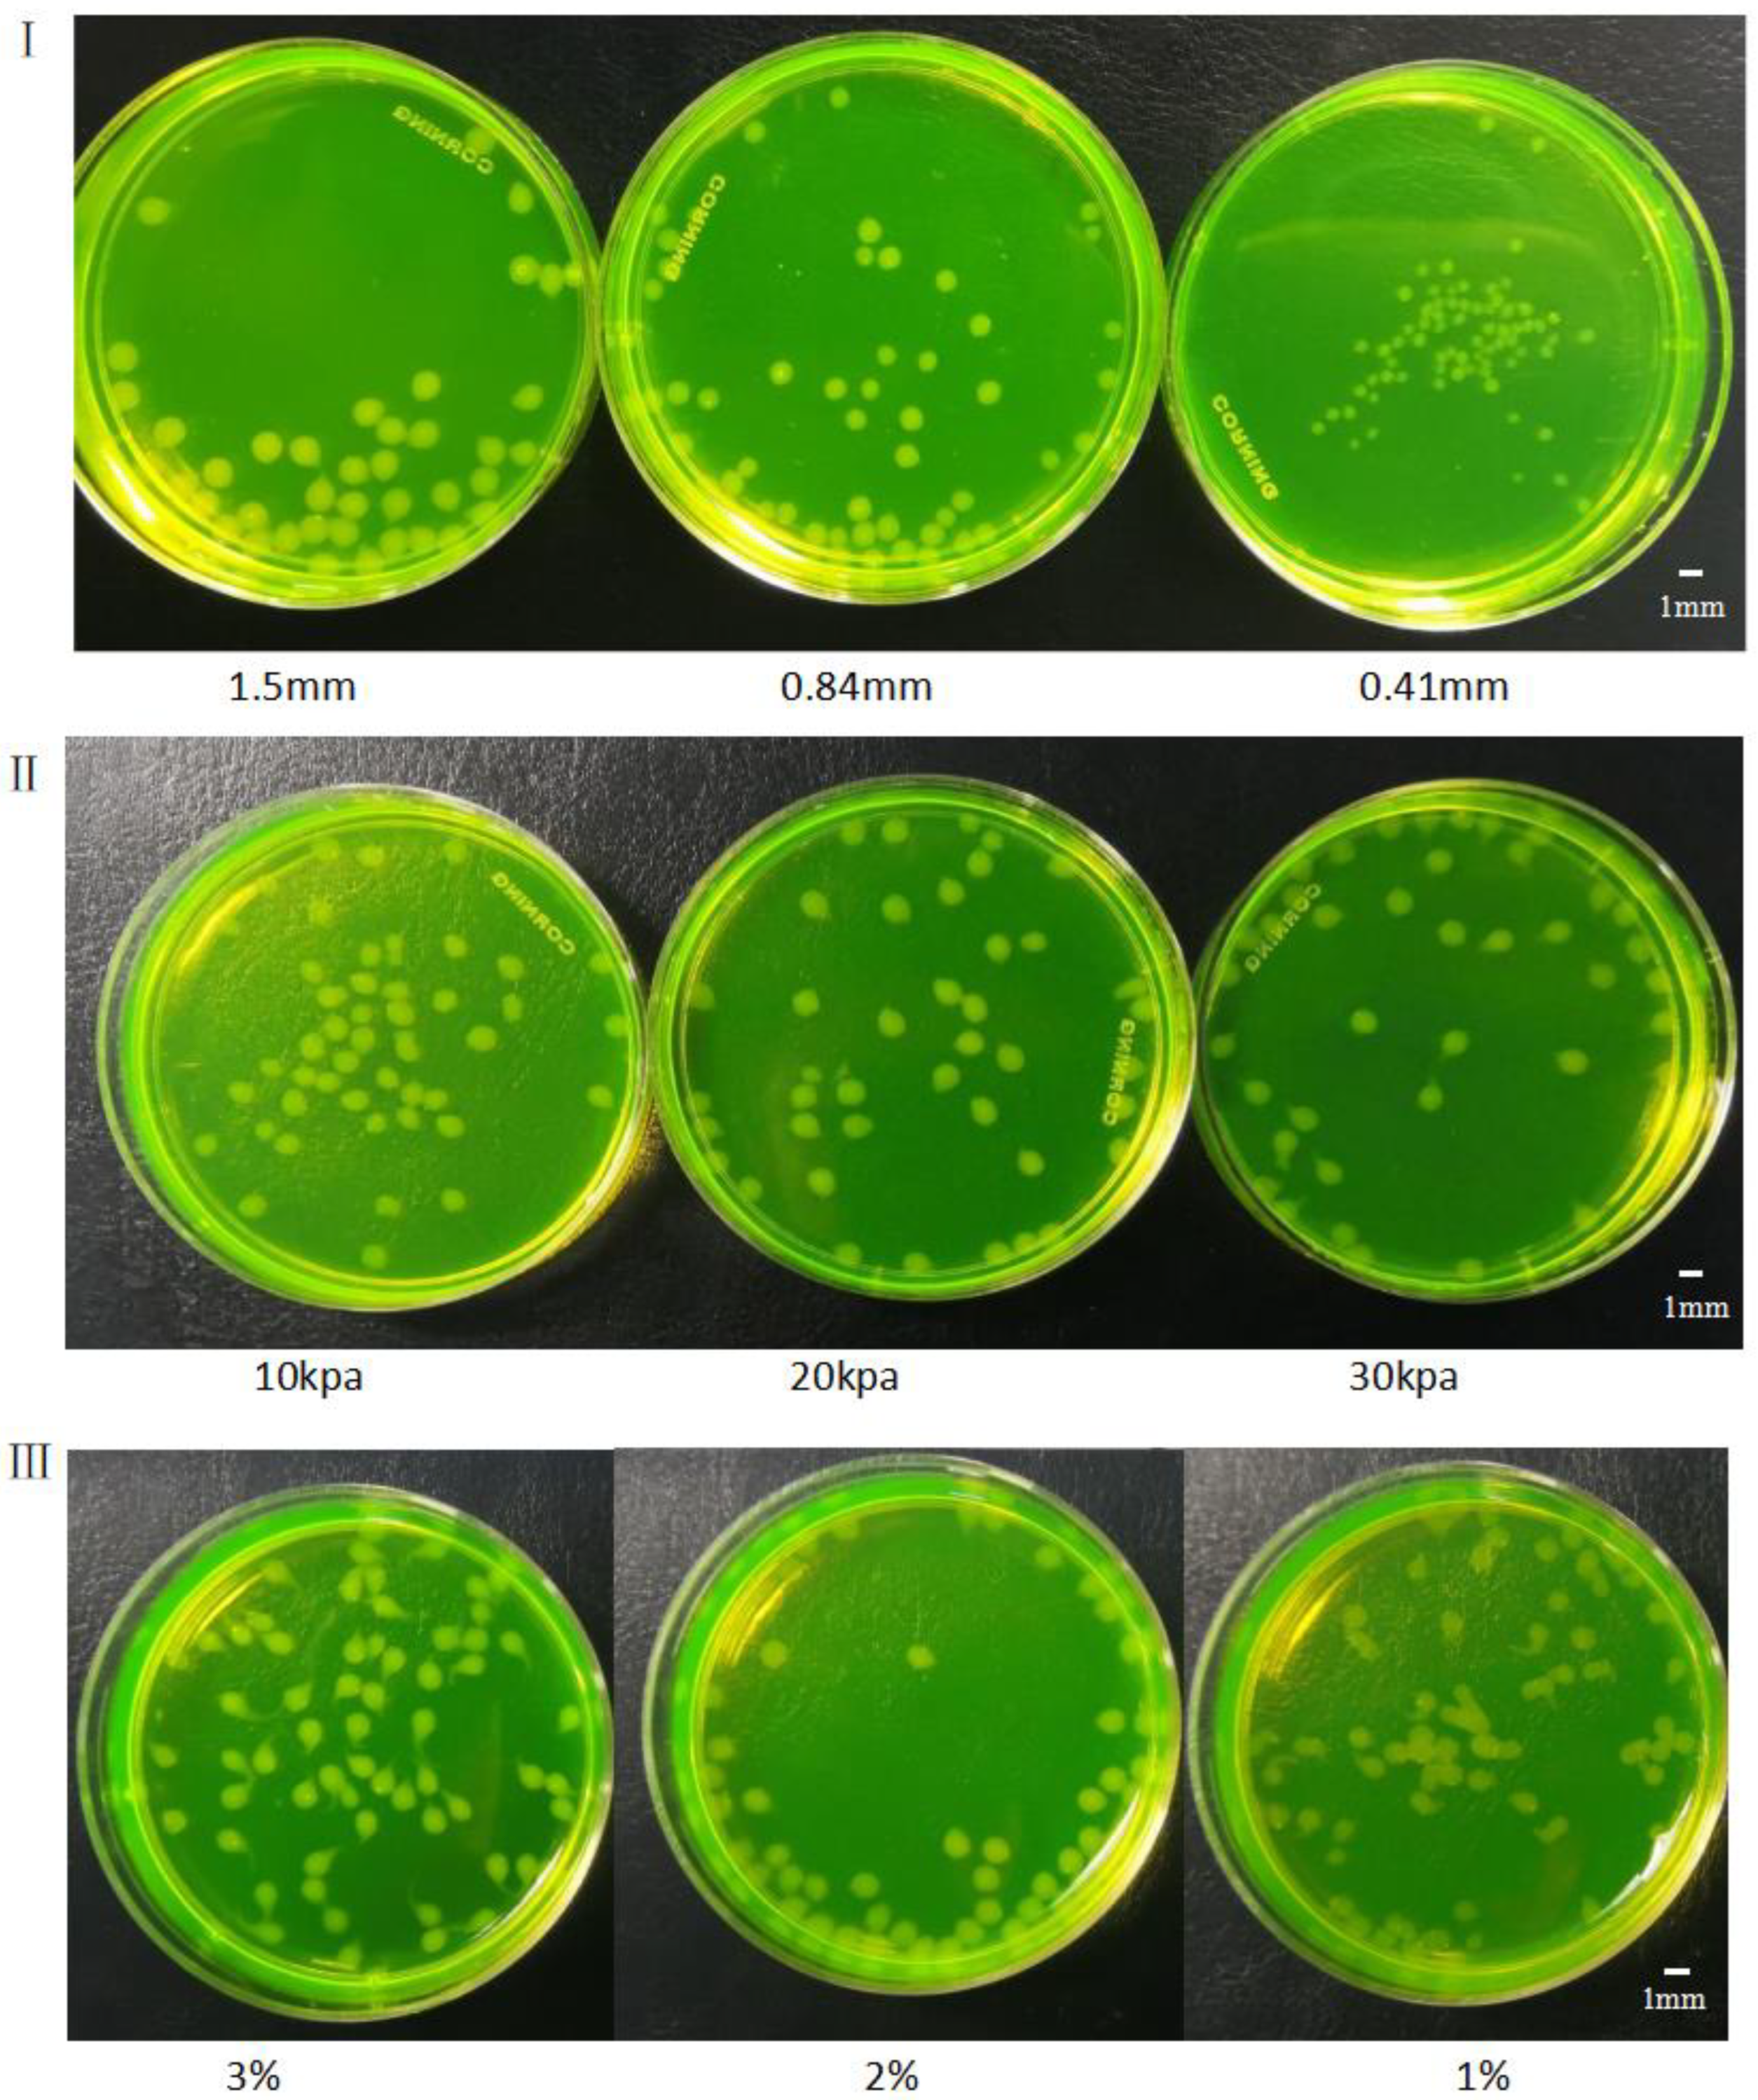

Gradient Printing Alginate Herero Gel Microspheres for Three-Dimensional Cell Culture
Abstract
:1. Introduction
2. Materials and Methods
2.1. Materials
2.2. Preparation of Alginate Gel Microspheres
2.3. Gel Microsphere Manufacturing Device
2.4. Processing Method of Gel Microspheres
2.5. Cell Assay Method
3. The Experimental Process, Results and Discussions
3.1. Properties of Sodium Alginate Solution
3.2. Mathematical Model of Mixing Process and Analysis of Factors Influencing the Mixing Alginate
3.2.1. Mathematical Model Analysis
3.2.2. Simulation of Mixing Process and Analysis
3.3. Effects of Different Factors on Formation of Gel Microspheres
3.4. Printed Gel Microspheres Containing Cells at Different Densities
4. Conclusions
Author Contributions
Funding
Institutional Review Board Statement
Informed Consent Statement
Data Availability Statement
Conflicts of Interest
References
- Rowinsky, E.K.; Eisenhauer, E.A.; Chaudhry, V.; Arbuck, S.G.; Donehower, R.C. Clinical toxicities encountered with paclitaxel (Taxol). Semin. Oncol. 1993, 20 (Suppl. S3), 1–15. [Google Scholar]
- Rusthoven, J.J.; Quirt, I.C.; Iscoe, N.A.; McCulloch, P.B.; James, K.W.; Lohmann, R.C.; Radoux, S.B.; Bodurtha, A.J.; Silver, H.K.; Verma, S.; et al. Randomized, double-blind, placebo-controlled trial comparing the response rates of carmustine, dacarbazine, and cisplatin with and without tamoxifen in patients with metastatic melanoma. National Cancer Institute of Canada Clinical Trials Group. J. Clin. Oncol. 1996, 14, 2083–2090. [Google Scholar] [CrossRef]
- Mitragotri, S.; Lahann, J. Physical approaches to biomaterial design. Nat. Mater. 2009, 8, 15–23. [Google Scholar] [CrossRef] [PubMed] [Green Version]
- Du, J.; O′reilly, R.K. Anisotropic particles with patchy, multicompartment and Janus architectures: Preparation and application. Chem. Soc. Rev. 2011, 40, 2402–2416. [Google Scholar] [CrossRef] [PubMed]
- Bäumler, H.; Georgieva, R. Coupled enzyme reactions in multicompartment microparticles. Biomacromolecules 2010, 11, 1480–1487. [Google Scholar] [CrossRef]
- Ohnuma, A.; Cho, E.C.; Camargo, P.H.; Au, L.; Ohtani, B.; Xia, Y. A facile synthesis of asymmetric hybrid colloidal particles. J. Am. Chem. Soc. 2009, 131, 1352–1353. [Google Scholar] [CrossRef] [PubMed] [Green Version]
- Christian, D.A.; Tian, A.; Ellenbroek, W.G.; Levental, I.; Rajagopal, K.; Janmey, P.A.; Liu, A.J.; Baumgart, T.; Discher, D.E. Spotted vesicles, striped micelles and Janus assemblies induced by ligand binding. Nat. Mater. 2009, 8, 843–849. [Google Scholar] [CrossRef] [PubMed]
- Walther, A.; Barner-Kowollik, C.; Müller, A.H.E. Mixed, multicompartment, or Janus micelles? A systematic study of thermoresponsive bis-hydrophilic block terpolymers. Langmuir 2010, 26, 12237–12246. [Google Scholar] [CrossRef]
- Mcconnell, M.D.; Kraeutler, M.J.; Yang, S.; Composto, R.J. Patchy and multiregion janus particles with tunable optical properties. Nano Lett. 2010, 10, 603–609. [Google Scholar] [CrossRef]
- Rasch, M.R.; Rossinyol, E.; Hueso, J.L.; Goodfellow, B.W.; Arbiol, J.; Korgel, B.A. Hydrophobic Gold Nanoparticle Self-Assembly with Phosphatidylcholine Lipid: Membrane-Loaded and Janus Vesicles. Nano Lett. 2010, 10, 3733–3739. [Google Scholar] [CrossRef]
- Weaver, J.V.; Rannard, S.P.; Cooper, A.I. Polymer-mediated hierarchical and reversible emulsion droplet assembly. Angew. Chem. Int. Ed. 2009, 121, 2165–2168. [Google Scholar] [CrossRef]
- Peppas, N.A.; Langer, R. New challenges in biomaterials. Science 1994, 263, 1715–1720. [Google Scholar] [CrossRef] [PubMed]
- Langer, R.; Tirrell, D.A. Designing materials for biology and medicine. Nature 2004, 428, 487–492. [Google Scholar] [CrossRef] [PubMed]
- Geng, Y.A.N.; Dalhaimer, P.; Cai, S.; Tsai, R.; Tewari, M.; Minko, T.; Discher, D.E. Shape effects of filaments versus spherical particles in flow and drug delivery. Nat. Nanotechnol. 2007, 2, 249–255. [Google Scholar] [CrossRef] [PubMed]
- Euliss, L.E.; DuPont, J.A.; Gratton, S.; DeSimone, J. Imparting size, shape, and composition control of materials for nanomedicine. Chem. Soc. Rev. 2006, 35, 1095–1104. [Google Scholar] [CrossRef] [PubMed]
- Shah, R.K.; Kim, J.W.; Weitz, D.A. Janus Supraparticles by Induced Phase Separation of Nanoparticles in Droplets. Adv. Mater. 2010, 21, 1949–1953. [Google Scholar] [CrossRef]
- Lone, S.; Kim, S.H.; Nam, S.W.; Park, S.; Joo, J.; Cheong, I.W. Microfluidic synthesis of Janus particles by UV-directed phase separation. Chem. Commun. 2011, 47, 2634–2636. [Google Scholar] [CrossRef] [PubMed]
- Seo, K.D.; Doh, J.; Kim, D.S. One-step microfluidic synthesis of Janus microhydrogels with anisotropic thermo-responsive behavior and organophilic/hydrophilic loading capability. Langmuir ACS J. Surf. Colloids 2013, 29, 15137–15141. [Google Scholar] [CrossRef] [PubMed]
- Choi, C.H.; Weitz, D.A.; Lee, C.S. One Step Formation of Controllable Complex Emulsions: From Functional Particles to Simultaneous Encapsulation of Hydrophilic and Hydrophobic Agents into Desired Position. Adv. Mater. 2013, 25, 2536–2541. [Google Scholar] [CrossRef] [PubMed]
- Min, N.G.; Ku, M.; Yang, J.; Kim, S.H. Microfluidic Production of Uniform Microcarriers with Multicompartments through Phase Separation in Emulsion Drops. Chem. Mater. 2016, 28, 1430–1438. [Google Scholar] [CrossRef]
- Wang, X.; Feng, X.; Ma, G.; Yao, L.; Ge, M. Amphiphilic Janus Particles Generated via a Combination of Diffusion-Induced Phase Separation and Magnetically Driven Dewetting and Their Synergistic Self-Assembly. Adv. Mater. 2016, 28, 3131–3137. [Google Scholar] [CrossRef] [PubMed]
- Paulsen, K.S.; Di, C.D.; Chung, A.J. Optofluidic fabrication for 3D-shaped particles. Nat. Commun. 2015, 6, 6976. [Google Scholar] [CrossRef] [PubMed] [Green Version]
- Habasaki, S.; Lee, W.C.; Yoshida, S.; Takeuchi, S. Vertical Flow Lithography for Fabrication of 3D Anisotropic Particles. Small 2015, 11, 6391–6396. [Google Scholar] [CrossRef]
- Fischlechner, M.; Schaerli, Y.; Mohamed, M.F.; Patil, S.; Abell, C.; Hollfelder, F. Evolution of enzyme catalysts caged in biomimetic gel-shell beads. Nat. Chem. 2014, 6, 791–796. [Google Scholar] [CrossRef]
- Choi, C.H.; Wang, H.; Lee, H.; Kim, J.H.; Zhang, L.; Mao, A.; Mooney, D.J.; Weitz, D.A. One-step generation of cell-laden microgels using double emulsion drops with a sacrificial ultra-thin oil shell. Lab A Chip 2016, 16, 1549–1555. [Google Scholar] [CrossRef] [PubMed] [Green Version]
- Martino, C.; Kim, S.H.; Horsfall, L.; Abbaspourrad, A.; Rosser, S.J.; Cooper, J.; Weitz, D.A. Protein Expression, Aggregation, and Triggered Release from Polymersomes as Artificial Cell-like Structures. Angew. Chem. Int. Ed. 2012, 51, 6416–6420. [Google Scholar] [CrossRef]
- Zhang, M.; Wang, W.; Xie, R.; Ju, X.; Liu, Z.; Jiang, L.; Chen, Q.; Chu, L. Controllable microfluidic strategies for fabricating microparticles using emulsions as templates. Particuology 2016, 24, 18–31. [Google Scholar] [CrossRef]
- Chu, L.Y.; Utada, A.S.; Shah, R.K.; Kim, J.W.; Weitz, D.A. Controllable Monodisperse Multiple Emulsions. Angew. Chem. Int. Ed. 2007, 46, 8970–8974. [Google Scholar] [CrossRef]
- Wang, W.; Xie, R.; Ju, X.J.; Luo, T.; Liu, L.; Weitz, D.A.; Chu, L.Y. Controllable microfluidic production of multicomponent multiple emulsions. Lab A Chip 2011, 11, 1587–1592. [Google Scholar] [CrossRef] [PubMed] [Green Version]
- Eun Chung, S.; Kim, J.; Yoon Oh, D.; Song, Y.; Hoon Lee, S.; Min, S.; Kwon, S. One-step pipetting and assembly of encoded chemical-laden microparticles for high-throughput multiplexed bioassays. Nat. Commun. 2014, 5, 3468–3480. [Google Scholar] [CrossRef] [Green Version]
- Qiu, C.; Chen, M.; Yan, H.; Wu, H. Generation of Uniformly Sized Alginate Microparticles for Cell Encapsulation by Using a Soft-Lithography Approach. Adv. Mater. 2010, 19, 1603–1607. [Google Scholar] [CrossRef]
- Juriga, D.; Kalman, E.E.; Toth, K.; Barczikai, D.; Szöllősi, D.; Földes, A.; Varga, G.; Zrinyi, M.; Jedlovszky-Hajdu, A.; Nagy, K.S. Analysis of Three-Dimensional Cell Migration in Dopamine-Modified Poly(aspartic acid)-Based Hydrogels. Gels 2022, 8, 65. [Google Scholar] [CrossRef] [PubMed]
- Billiet, T.; Gevaert, E.; De Schryver, T.; Cornelissen, M.; Dubruel, P. The 3D printing of gelatin methacrylamide cell-laden tissue-engineered constructs with high cell viability. Biomaterials 2014, 35, 49–62. [Google Scholar] [CrossRef] [PubMed]
- Christensen, K.; Xu, C.; Chai, W.; Zhang, Z.; Fu, J.; Huang, Y. Freeform inkjet printing of cellular structures with bifurcations. Biotechnol. Bioeng. 2015, 112, 1047–1055. [Google Scholar] [CrossRef] [PubMed]

| The Name of the Reagent | Specifications | Company |
|---|---|---|
| Fetal bovine serum (FBS) | Biological level | Sigma-Aldrich (Germany) |
| DMEM medium | Cell culture level | Sigma-Aldrich (Germany) |
| Penicillin-Streptomycin solution | Biological level | Sigma-Aldrich (Germany) |
| 0.25% Sterile PBS buffer | Cell culture level | Sigma-Aldrich (Germany) |
| Phosphate-buffered saline (PBS, pH: 7.4) | Cell culture level | Sigma-Aldrich (Germany) |
| 75% Medical alcohol | Analytical Reagent | Merck (Germany) |
| Anhydrous calcium chloride | Analytical Reagent | Fluka (Switzerland) |
| Sodium alginate | Analytical Reagent | Fluka (Switzerland) |
| DMSO | Sigma-Aldrich (Germany) | |
| Calcein | K305-1000 | Sigma-Aldrich (Germany) |
| Propidium iodide | DMEM/F-12, HEPES | Merck (Germany) |
| Deionized water |
Publisher’s Note: MDPI stays neutral with regard to jurisdictional claims in published maps and institutional affiliations. |
© 2022 by the authors. Licensee MDPI, Basel, Switzerland. This article is an open access article distributed under the terms and conditions of the Creative Commons Attribution (CC BY) license (https://creativecommons.org/licenses/by/4.0/).
Share and Cite
Gong, Y.; Chen, H.; Li, W.; Zhou, C.; Zhou, R.; Zhao, H.; Shao, H. Gradient Printing Alginate Herero Gel Microspheres for Three-Dimensional Cell Culture. Materials 2022, 15, 2305. https://doi.org/10.3390/ma15062305
Gong Y, Chen H, Li W, Zhou C, Zhou R, Zhao H, Shao H. Gradient Printing Alginate Herero Gel Microspheres for Three-Dimensional Cell Culture. Materials. 2022; 15(6):2305. https://doi.org/10.3390/ma15062305
Chicago/Turabian StyleGong, Youping, Honghao Chen, Wenxin Li, Chuanping Zhou, Rougang Zhou, Haiming Zhao, and Huifeng Shao. 2022. "Gradient Printing Alginate Herero Gel Microspheres for Three-Dimensional Cell Culture" Materials 15, no. 6: 2305. https://doi.org/10.3390/ma15062305
APA StyleGong, Y., Chen, H., Li, W., Zhou, C., Zhou, R., Zhao, H., & Shao, H. (2022). Gradient Printing Alginate Herero Gel Microspheres for Three-Dimensional Cell Culture. Materials, 15(6), 2305. https://doi.org/10.3390/ma15062305

